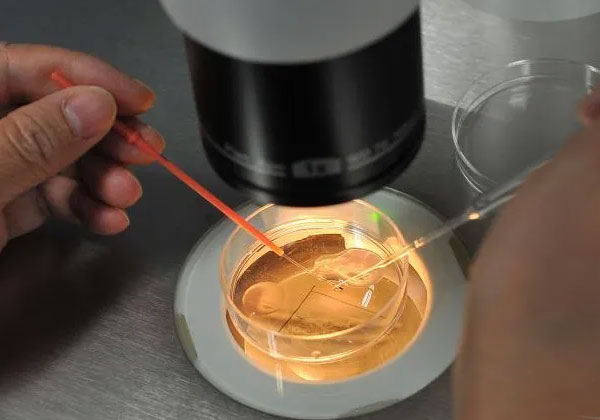
养囊第二天没出囊还有希望，但要受精卵异常可能停止发育

-

剖腹产看得出来之前人流过 虽然看不出 但要跟医
剖腹产看得出来之前人流过吗?这是近几天大家问的比较多的一个问题。严格意义上来说,如果一个女人选择剖腹产的方式,医生是看不出来的。不过,有过生孩子经历的人应该都知..
2023-04-11 07:05 -
江南殡仪馆火化工-殡仪馆招火化工,事业编制!但要求大学本科、经济类专业…
单位名称:重庆四公里江南殡仪馆服务类别:殡仪馆、火葬场项目优势:一级殡仪馆、遗体火化、守灵治丧、丧葬用品、鲜花灵堂、餐饮服务单位地址:重庆市南岸区四公里广黔路80..
2023-12-16 14:33 -

第三胎想要儿子可以去医院做试管,但要满足三大条件!
第三胎想要儿子可以去医院做试管,但要满足三大条件!随着老龄化的到来,国家放开了二胎、三胎政策,很多育龄家庭都有生三胎的计划,但可能因为年龄或不孕不育的原因而推迟..
2024-03-02 09:05 -

FSH值大于25一年后会面临绝经吗?不一定,但要及时治疗调理
不管是备孕前的检查还是做试管前的检查,女性都会被要求检查性激素六项,其中有一项叫作FSH的数值,它的值对女性的卵巢功能有一定的预示作用。如果当女性朋友看到自己的FSH..
2024-08-08 09:40 -

试管移植成功后可不可以做饭?但要注意这些事项
试管移植后一般是可以自己做饭的。检查一切正常,是可以适当做些简单的事情的。试管婴儿移植后一般可正常生活,如果工作不是那种高度紧张或重体力的,也可正常上班的,一直..
2024-09-03 09:14 -

fsh高于19还可以做试管吗,可以,但要抓紧时间才有希望
当女性fsh数值高于19时还可以做试管吗?不孕不育的人群中,他们想要生育最佳的方式就是选择试管婴儿技术助孕了。在需要通过试管助孕的女性朋友有些可能还普遍存在的问题就..
2024-09-18 09:28 -

科普: 国内供卵试管婴儿是合法的,但要满足这三个条件才能申请!
供卵试管婴儿违法吗?供卵试管婴儿,又名赠卵试管婴儿,或借卵试管婴儿,是指女性由于卵巢储备衰竭或其他遗传疾病等原因自有卵子不能使用的情况下,可以借助试管婴儿技术,..
2024-09-18 10:12 -

坐月子可以吃虾吗-没有过敏现象可以吃虾,但要把握量和烹饪的方式
在日常生活中,产妇的饮食健康是非常重要的,因此很多东西产妇都是不能吃的。而很多喜欢吃虾的孕妈在孕期为了怕过敏都选择不吃,那么坐月子期间可以吃虾吗?接下来就和小编..
2024-09-22 09:05 -

国内试管婴儿试管婴儿是合法的「但要满足特定条件」
很多人在问在国内做试管婴儿试管婴儿合法吗?做试管婴儿试管婴儿会坐牢吗?风险大不大?今天小编将为你就试管婴儿试管婴儿的合法性问题给大家详细解读。国内试管婴儿试管婴..
2024-10-04 09:24 -

高龄已经绝经还可以做试管婴儿试管婴儿吗-可以但要分情况而论
绝经是女性必经的一个正常的生理过程,女性到了45~55岁的时候,都会逐步出现绝经的现象。说到绝经,很多女性都会感到害怕,因为它往往提示着卵巢功能退化,丧失生育能力以..
2024-10-15 10:38 -

amh值太低了还能做试管婴儿吗?可以!但要注意时间不等人!
说到生育能力评估,就不得不提及一个关键词:AMH。AMH全名叫做抗缪勒氏管激素,是反映评估女性生殖能力高低的重要参数,一般来说AMH的正常值在2~6.8ng/ml之间,数值范围内..
2024-10-21 09:27 -
养囊第二天没出囊还有希望,但要受精卵异常可能停止发育
养囊一般要5-6天,就会出结果,而养囊的操作是需要先将培育好的受精卵进行培养。卵子和精子形成受精卵后不断的分裂,在第3天形成5-10个细胞组成的胚胎,就是常说的第3天胚..
2024-11-19 10:24 -

孕妇感冒咳嗽对胎儿有影响吗?一般影响不大,但要注意预防
孕妇的身体健康状况会影响到胎儿的生长发育,那么孕妇在孕期就要格外注意自己的身体状况,特别要警惕孕期会出现感冒的情况,以内免疫力会比一办女性要低一些,然而就比较容..
2024-11-26 10:26 -

刚做完试管婴儿移植可以吃榴莲吗?可以,但要注意适量
胚胎移植是试管婴儿技术中的最后一个环节,也是非常关键的一步。很多姐妹移植后就变得极为紧张,生怕有任何风吹草动影响了胚胎着床。经常有姐妹焦急地询问:移植后什么能吃..
2024-12-31 10:57 -

38岁无精症晚育夫妻可以做试管婴儿吗-可以但要先分析具体病症
试管婴儿技术是目前解决不孕不育最有效的方法之一。对于男性无精症现在占男性不育的20%左右,是一种比较难治疗的疾病。给许多的不孕不育家庭带来了很大的压力,无精症一般..
2025-01-04 09:25 -

让小孩子看电视,但要坚守四个原则
一到周末,小孩子就开始缠着大人要看电视,不让看就开始在家里使劲作,为求得一分清净,家长只好妥协,接下来,双方相安无事。但是,放任孩子这样看电视到底好不好呢?小编..
2025-01-29 09:06 -

卵巢早衰amh1.6能试管吗?能,但要当心取卵数量比基础卵泡少
卵巢早衰amh1.6能试管,虽然amh值1.6代表女性卵巢储备功能不足,自然怀孕几率严重降低,但通过试管婴儿促排卵治疗是能够取得可用卵子的,但要当心取卵数量比基础卵泡少。一..
2025-02-19 09:08 -

专家答疑高龄腺肌症能做试管婴儿-但要尽早
腺肌症也就是子宫腺肌症,是指子宫内膜腺体和间质入侵了子宫肌层,造成了弥漫或是局部的病变,腺肌症给女性带来的危害很大,严重的话会造成女性不孕,这对女性无疑是一个巨..
2025-05-11 09:39 -

幼稚子宫还能做试管婴儿怀孕吗-可以但要先治疗
幼稚子宫是否可以做试管婴儿,具体需要看患者的子宫的具体大小,如果现在有正常的月经,那么可以通过治疗还是有希望自然怀孕的。如果特别小的话,那么自然怀孕的几率很小,..
2025-05-31 09:24 -

女性弓形子宫能做试管婴儿吗-可以但要先治疗
都知道子宫是女性孕育孩子的“宫殿”,健康的子宫才可以培育出小宝宝,可是,并并不一定女性的子宫全是健康的,有的女性子宫也有先天的发育不全,而变成了别的的样子。那么..
2025-06-03 09:00
微信分享
扫描二维码分享到微信或朋友圈